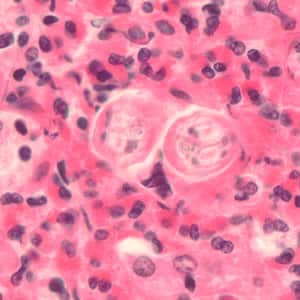

Toxocariasis
[Toxocara canis] [Toxocara cati]
Causal Agents
Toxocariasis in humans is caused by infection with larvae of Toxocara spp., which are common ascarid roundworms of mammals. Confirmed zoonotic species include the dog roundworm T. canis (presumed most common) and the cat roundworm T. cati (frequency not known). It is not known whether other closely-related Toxocara species can infect humans (e.g. T. malaysiensis of cats).
Life Cycle
 . Eggs embryonate over a period of 1 to 4 weeks in the environment and become infective, containing third-stage (L3) larvae
. Eggs embryonate over a period of 1 to 4 weeks in the environment and become infective, containing third-stage (L3) larvae  . Following ingestion by a definitive host
. Following ingestion by a definitive host  , the infective eggs hatch and larvae penetrate the gut wall. In younger dogs (T. canis) and in cats (T. cati), the larvae migrate through the lungs, bronchial tree, and esophagus, where they are coughed up swallowed into the gastrointestinal tract; adult worms develop and oviposit in the small intestine
, the infective eggs hatch and larvae penetrate the gut wall. In younger dogs (T. canis) and in cats (T. cati), the larvae migrate through the lungs, bronchial tree, and esophagus, where they are coughed up swallowed into the gastrointestinal tract; adult worms develop and oviposit in the small intestine  . In older dogs, patent (egg-producing) infections can also occur, but larvae more commonly become arrested in tissues. Arrested larvae are reactivated in female dogs during late gestation and may infect pups by the transplacental (major) and transmammary (minor) routes
. In older dogs, patent (egg-producing) infections can also occur, but larvae more commonly become arrested in tissues. Arrested larvae are reactivated in female dogs during late gestation and may infect pups by the transplacental (major) and transmammary (minor) routes  in whose small intestine adult worms become established
in whose small intestine adult worms become established  . In cats, T. cati larvae can be transmitted via the transmammary route
. In cats, T. cati larvae can be transmitted via the transmammary route  to kittens if the dam is infected during gestation, but somatic larval arrest and reactivation does not appear to be important as in T. canis.
to kittens if the dam is infected during gestation, but somatic larval arrest and reactivation does not appear to be important as in T. canis.Toxocara spp. can also be transmitted indirectly through ingestion of paratenic hosts. Eggs ingested by suitable paratenic hosts hatch and larvae penetrate the gut wall and migrate into various tissues where they encyst
 . The life cycle is completed when definitive hosts consume larvae within paratenic host tissue
. The life cycle is completed when definitive hosts consume larvae within paratenic host tissue  , and the larvae develop into adult worms in the small intestine.
, and the larvae develop into adult worms in the small intestine.Humans are accidental hosts who become infected by ingesting infective eggs
 or undercooked meat/viscera of infected paratenic hosts
or undercooked meat/viscera of infected paratenic hosts  . After ingestion, the eggs hatch and larvae penetrate the intestinal wall and are carried by the circulation to a variety of tissues (liver, heart, lungs, brain, muscle, eyes)
. After ingestion, the eggs hatch and larvae penetrate the intestinal wall and are carried by the circulation to a variety of tissues (liver, heart, lungs, brain, muscle, eyes)  . While the larvae do not undergo any further development in these sites, they can cause local reactions and mechanical damage that causes clinical toxocariasis.
. While the larvae do not undergo any further development in these sites, they can cause local reactions and mechanical damage that causes clinical toxocariasis.Hosts
Toxocara canis infects essentially all wild and domestic canids; patent infections are more prevalent among puppies than older dogs. T. cati is found in wild and domestic felids of all ages, but patent infections are slightly more common in kittens.
Paratenic host ranges for both species encompass numerous species of mammals and birds. Livestock are important paratenic hosts; some human cases have been linked to consumption of undercooked beef, lamb, chicken, and duck meat (particularly liver). Cockroaches and earthworms have been experimentally infected, and could possibly serve as paratenic or transport hosts.
Geographic Distribution
Toxocara canis and T. cati are cosmopolitan parasites of domestic dogs and cats. While common globally, prevalence in both animals and people is highest in developing countries. In developed countries, more infections are detected among persons in lower socioeconomic strata.
Clinical Presentation
The main clinical presentations of toxocariasis are visceral larva migrans (VLM) and ocular larva migrans (OLM), although most infections are asymptomatic. In VLM, which occurs mostly in preschool children, the larvae invade multiple tissues (commonly liver, lung, skeletal muscle, occasionally heart) and cause various nonspecific symptoms (e.g. fever, myalgia, weight loss, cough, rashes, hepatosplenomegaly) usually accompanied by hypereosinophilia.
Migration to the central nervous system (neurotoxocariasis or neural larva migrans (NLM)) is uncommon and can cause eosinophilic meningoencephalitis. Death can occur in instances of severe cardiac, pulmonary, or neurologic involvement.
In OLM, the larvae produce various ophthalmologic lesions, and may cause diffuse unilateral subacute neuroretinitis (DUSN). Involvement is typically unilateral (affecting one eye) and associated visual impairment usually presents with uveitis, retinitis, or endophthalmitis; permanent visual damage or blindness can occur. Associated larval granulomas have in some cases have been misdiagnosed as retinoblastoma. OLM most often occurs in older children or young adults, who uncommonly have visceral manifestations.
Toxocara sp. eggs.
Eggs are not clinically diagnostic for human cases as humans are incapable of harboring adult worms that pass eggs. Humans are paratenic hosts for Toxocara spp. and eggs are found only in the feces of definitive hosts (cats and dogs). Toxocara eggs are golden in color, spherical to slightly pear shaped, thick-shelled, and have a pitted surface. The size range for different species varies slightly; T. canis is slightly larger (80—85 µm) than T. cati (65—75 µm). Toxocara sp. eggs are extremely hardy and can persist in the environment for years.



Toxocara spp. develop to third stage (L3) larvae in ovo. When hatched, L3 larvae are about 350—400 µm long and about 15—20 µm in maximum width, with a straight esophagus extending about a third of the body length.



Adult Toxocara sp. worms.
Adult Toxocara spp. measure approximately 4—6 cm long (males) and 6—10 cm long (females). Like all ascarids, Toxocara have three “lips” on the anterior end of the worm. They also possess large, spear-shaped cervical alae, which are broader in T. cati than T. canis..






Toxocara sp. in tissue sections stained with hematoxylin and eosin.
In tissue, Toxocara spp. larvae are 15—20 µm wide in lateral sections and are often found surrounded by a granulomatous reaction. Two large excretory columns are present and single-pointed lateral alae are conspicuous along most of the body length. Their overall appearance is very similar to but smaller than Baylisascaris procyonis (which is typically 45—65 µm in width).

Laboratory Diagnosis
Diagnosis of toxocariasis relies mostly on indirect means, particularly serology, since larvae are trapped in tissues and not readily detected morphologically. While visualization of larvae in histologic sections provides unequivocal diagnosis, the probability of capturing a larva in a small biopsy specimen is low. Since the larvae do not develop into adults in humans, a stool examination would not detect any Toxocara eggs. For both VLM and OLM, a presumptive diagnosis rests on clinical signs, compatible exposure history (e.g. history of exposure to puppies/kittens or pica/geophagia behaviors), laboratory findings (including eosinophilia), and the detection of antibodies to Toxocara.
Antibody Detection
Antibody detection tests are the only means of confirmation of a clinical diagnosis of visceral larva migrans (VLM) and ocular larva migrans (OLM), clinical syndromes associated with Toxocara infections. The currently recommended serologic test for toxocariasis is enzyme immunoassay (EIA) with larval stage antigens extracted from embryonated eggs or released in vitro by cultured third-stage larvae. The latter, Toxocara excretory-secretory (TES) antigens, are preferable to larval extracts because they are convenient to produce and an absorption-purification step is not required for obtaining maximum specificity.
The TES-ELISA used at CDC measures total Toxocara-specific immunoglobulin and results are reported as an endpoint titer (<1:2, 1:2, 1:4, 1:16, etc.). A titer of ≥1:32 is considered positive. Evaluation of this assay in groups of patients with presumptive diagnoses of VLM or OLM indicated sensitivity of 78% and 73%, respectively, at a titer of ≥1:32. . Further confirmation of serologic diagnosis of OLM can be obtained by testing aqueous or vitreous humor samples for antibodies. Specificity has been reported to be 92% (VLM) and 91% (OLM) at a titer of ≥1:32 (serum).
Special considerations:
- The assay detects infections caused by both T. canis and T. cati but cannot differentiate between the two.
- Evaluation of the true sensitivity and specificity of serologic tests for toxocariasis in human populations is not possible because of the lack of feasible parasitological methods to detect migrating Toxocara larvae in tissue. These inherent problems result in underestimations of sensitivity and specificity.
- When interpreting serologic findings, clinicians must be aware that a measurable titer does not necessarily indicate current clinical Toxocara infection. In most human populations, a small number of those tested have positive EIA titers that apparently reflect the prevalence of asymptomatic toxocariasis, or past infections that have since been cleared. Positive serological results should always be interpreted with consideration of the patient’s clinical picture. Paired serum samples demonstrating a significant rise in antibody level over time may be useful to confirm active infection.
Laboratory safety
Standard precautions for the examination of histological sections or processing of serum samples apply.
Suggested Readings
Moreira, G.M.S.G., de Lima Telmo, P., Mendonça, M., Moreira, Â.N., McBride, A.J.A., Scaini, C.J. and Conceição, F.R., 2014. Human toxocariasis: current advances in diagnostics, treatment, and interventions. Trends in Parasitology, 30 (9), pp.456-464.
Fillaux, J. and Magnaval, J.F., 2013. Laboratory diagnosis of human toxocariasis. Veterinary Parasitology, 193 (4), pp.327-336.
Fisher, M., 2003. Toxocara cati: an underestimated zoonotic agent. Trends in Parasitology, 19(4), pp.167-170.
DPDx is an educational resource designed for health professionals and laboratory scientists. For an overview including prevention, control, and treatment visit www.cdc.gov/parasites/.

